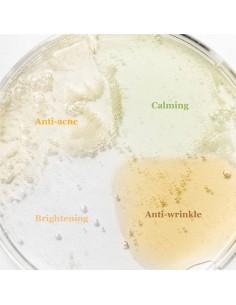

Trata y calma rápidamente la piel sensible y propensa a brotes con este potente suero cargado con 10,000ppm de agua de hoja de árbol de té y un 14.5% de centella asiática. La fórmula también incluye AHAs, BHAs y PHAs para exfoliar suavemente, además de una doble capa de aceites de origen vegetal para mantener la hidratación bloqueada.
INGREDIENTES CLAVE
-AHA (Ácido Alfa Hidroxiácido):
Ayuda a exfoliar la capa superficial de la piel, mejorando la textura y el tono.
-BHA (Ácido Beta Hidroxiácido): Penetra profundamente en los poros para limpiar el exceso de sebo y las impurezas.
-PHA (Ácido Poli Hidroxiácido): Exfoliante suave que ayuda a hidratar la piel y fortalecer la barrera cutánea.
-Tea Tree Leaf Water: Conocido por sus propiedades antiinflamatorias y antibacterianas, ideal para tratar el acné.
-Extractos de Centella Asiática, Aloe Vera y Witch Hazel: Calman e hidratan la piel, ayudando a reducir la irritación.
BENEFICIOS
-Exfoliación Suave: Ayuda a eliminar las células muertas de la piel y promueve la renovación celular.
-Limpieza Profunda: Desobstruye los poros y ayuda a controlar el exceso de sebo.
-Hidratación y Calma: Mantiene la piel hidratada y calmada, reduciendo la irritación y la inflamación.
-Mejora del Tono y Textura de la Piel: Contribuye a una piel más suave, uniforme y radiante.
MODO DE EMPLEO
Limpieza: Después de limpiar el rostro, aplica el tónico con un disco de algodón o vierte una cantidad adecuada en las manos.
Aplicación: Aplica suavemente sobre el rostro evitando el área de los ojos y labios.
Absorción: Deja que se absorba completamente en la piel antes de aplicar otros productos de cuidado facial.
TIPO DE PIEL
-Piel grasa, mixta y propensa al acné.
-Piel sensible que necesita exfoliación suave y tratamiento contra el acné.
INCI
Caprylic/Capric Triglyceride, Cetyl Ethylhexanoate, Centella Asiatica Extract (14.51%), Water, Olive Oil, Glycerin, Propanediol, Butylene Glycol, Ethanol, 1,2-Hexanediol, Tea Tree Leaf Water, Niacinamide, Green Tea Extract, Scutellaria Baicalensis Root Extract, Polygonum Cuspidatum Root Extract, Licorice Root Extract or Licorice Root Extract, Matricaria Flower Extract, Rosemary Leaf Extract, Citric Acid, Sodium Lactate, Sodium PCA, Glycolic Acid, Lactic Acid, Malic Acid, Pyruvic acid, Tartaric acid, Gaultheria Procumbens Leaf Extract, Cranberry Extract, Lavender Extract, Basil Leaf Extract, Lilac Extract, Houttuynia Cordata Extract, Tea Chrysanthemum, Althaea Officinalis Root Extract, Rosemary Extract, Madecassoside, Camellia Oleifera Seed Oil, Rice Bran Oil, Camellia Sinensis Seed Oil, Rosa Canina Fruit Oil, Sweet Almond Oil, Meadowfoam Seed Oil, Sodium chloride, Turmeric Root Extract, Grapefruit Peel Oil, Orange Peel Oil, Melia Azadirachta Leaf Extract, Melia Azadirachta Flower Extract, Melia Azadirachta Bark Extract, Pearl powder, Xanthan Gum, Pentylene Glycol, Moringa oleifera, Ocimum Sanctum Leaf Extract, Basil Flower/leaf Extract, Pelargonium Graveolens Flower Oil, Frankincense Oil, Amyris Balsamifera Bark Oil, Disodium EDTA, Caprylyl Glycol, Ethylhexylglycerin
INFORMACIÓN RSGP
Responsable en Europa del producto y dirección: Cosibella Sp. z o. o. Dirección: ul. Jutrzenki 177, 02-231 Varsovia, REGON 385746050, NIP 5223180504
E-mail del responsable: zamowienia@cosibella.pl
Página Web del Responsable: https://cosibella.pl/
Precauciones PIF: Producto para uso externo únicamente. No utilizar sobre piel dañada. Si aparece cualquier signo de irritación, suspenda el uso del producto. Mantener fuera del alcance de los niños. Conservar el producto a temperatura ambiente, en un lugar sombreado. Las fluctuaciones de temperatura durante el transporte no afectarán la estabilidad ni las propiedades del producto.
 Preferencias sobre cookies
Preferencias sobre cookies